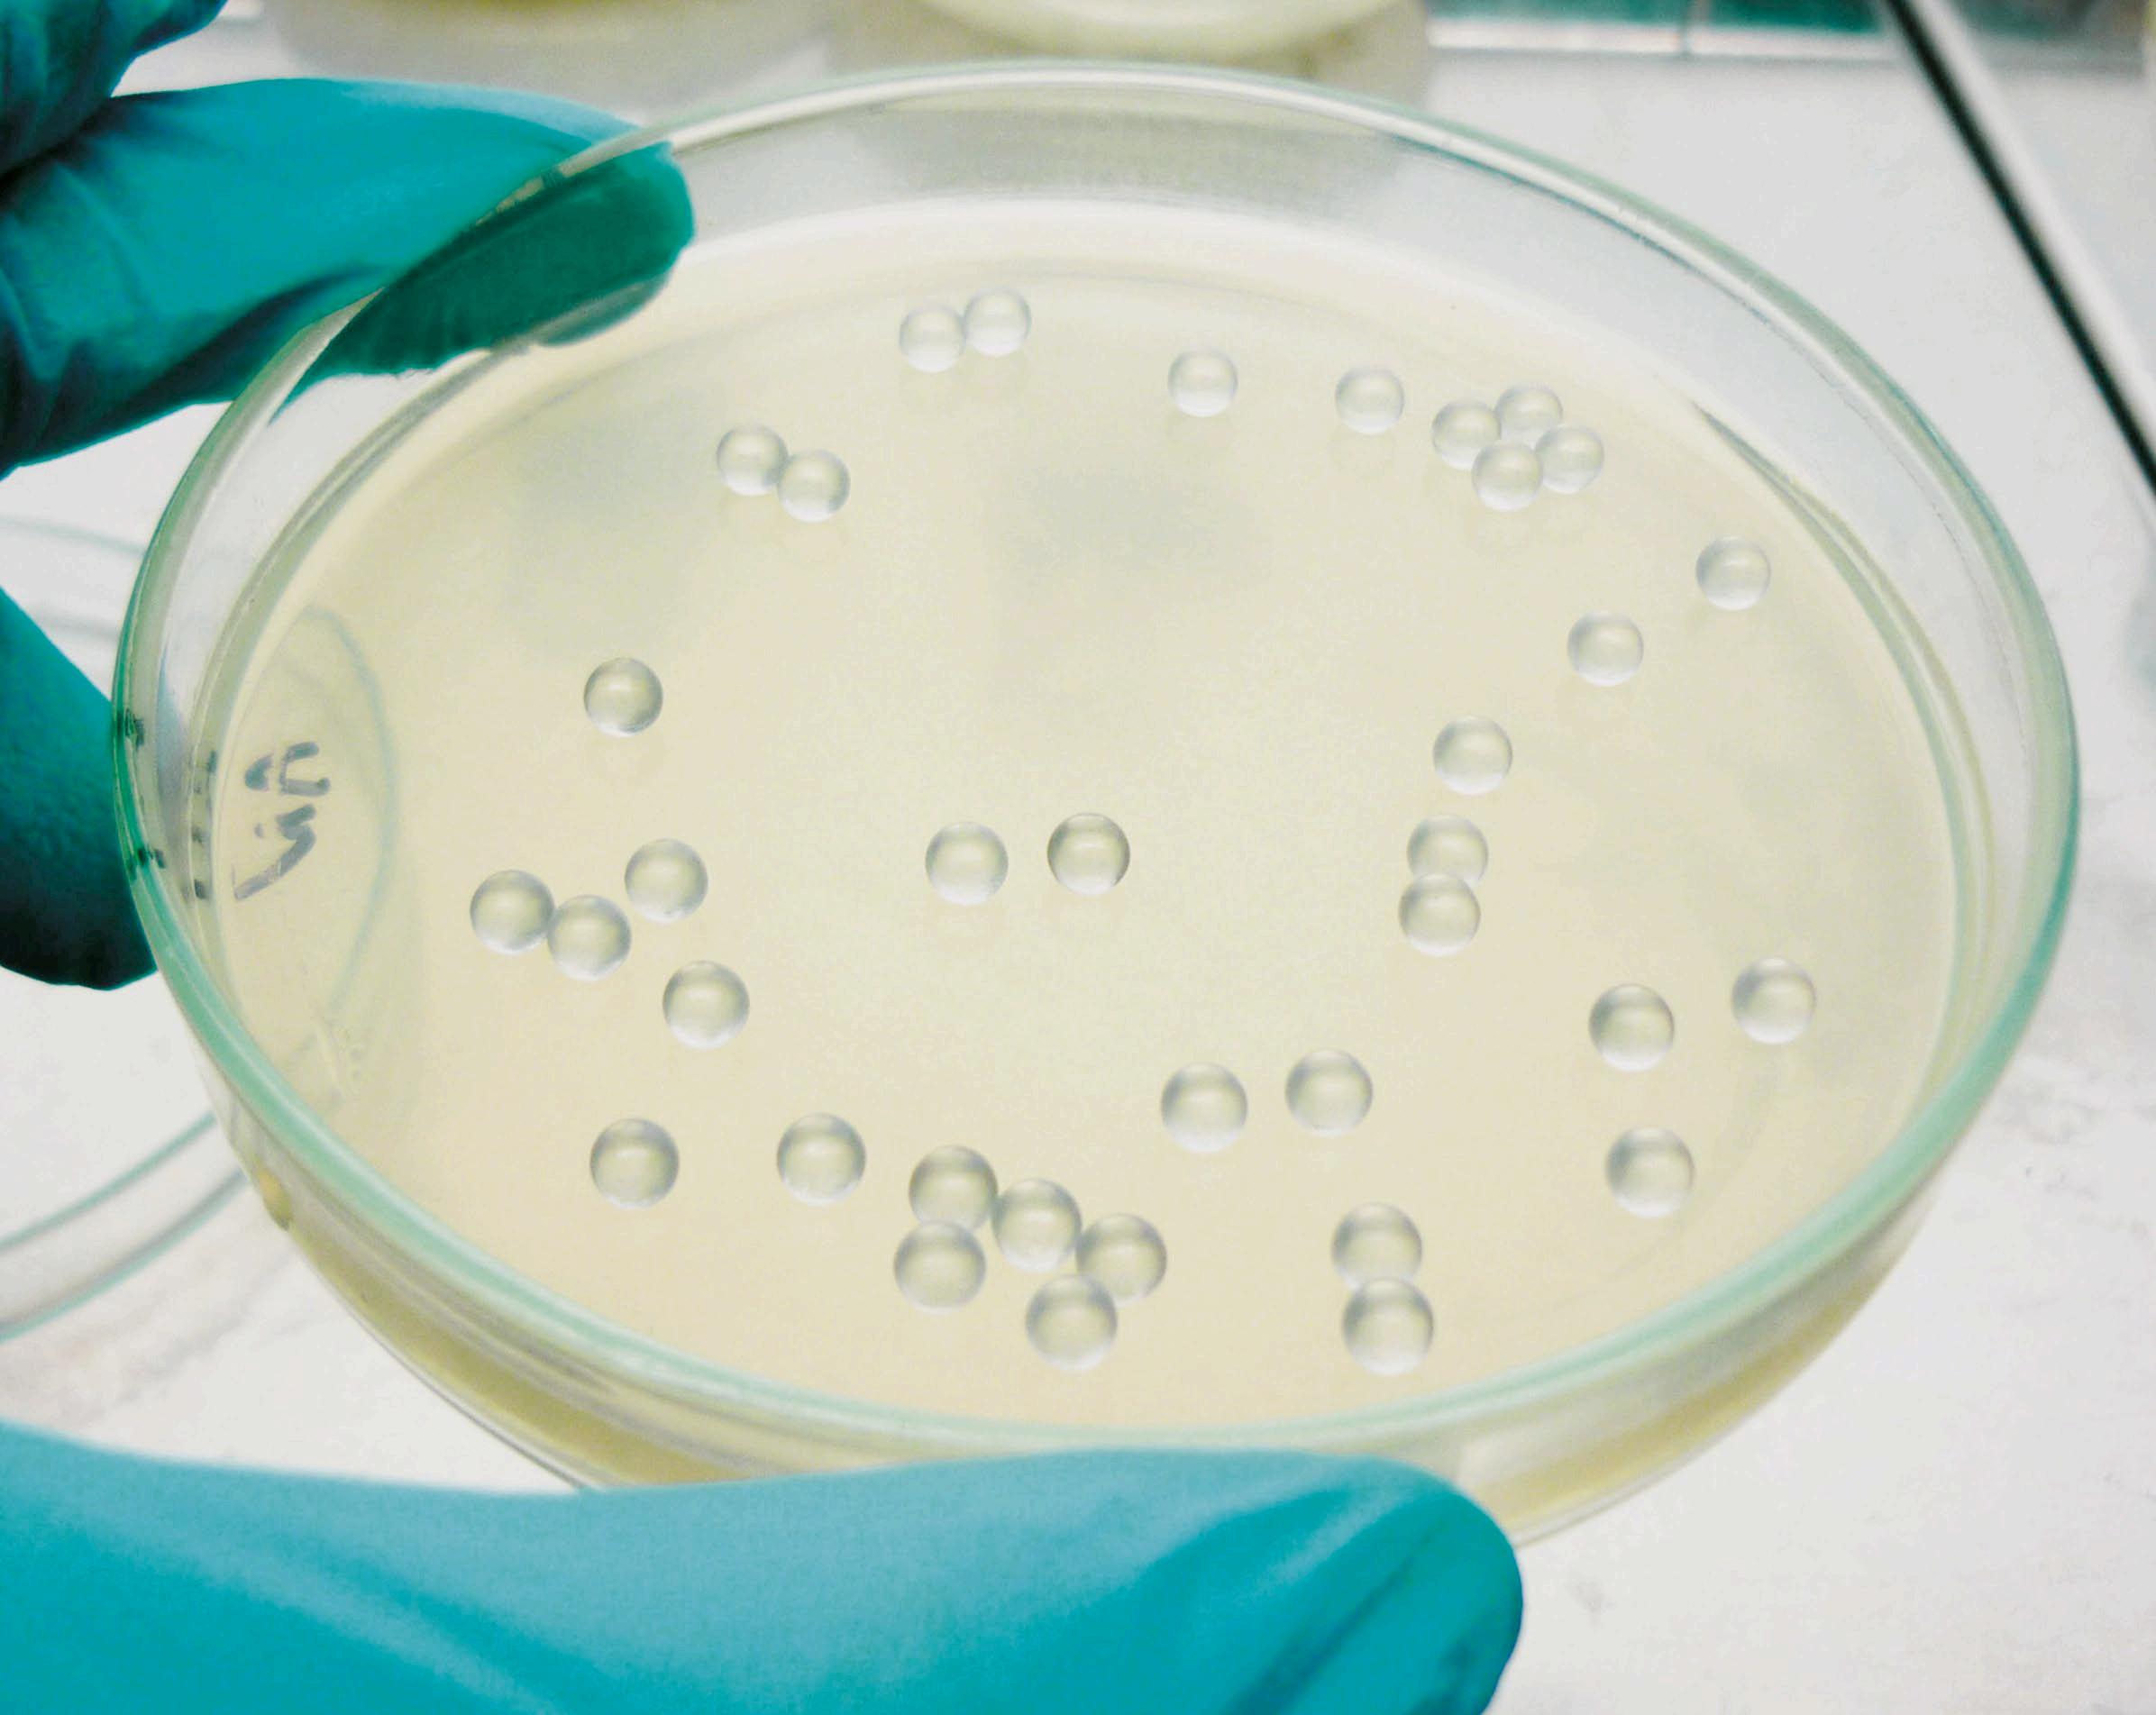

![]()
















Learn about the latest dry granulation innovations available only on GERTEIS® roller compactors. Introducing our cutting-edge In-Line Density Measurement Solution, the new Ultra Small Amount Funnel and the Design of Experiments Software Feature!
PAT: In-Line Density Measurement
Real-Time Insights: Say goodbye to off-line testing delays. Our system provides instant density measurements during production, allowing timely adjustments and informed decision-making.

High Precision: Accurate density data is key to robust process control. Whether you’re scaling up or down, our system ensures reliable results.




























Closed-Loop Feedback: Linking density measurements to process parameters enables dynamic adjustments. Stay ahead of variations and maintain product consistency.
Design: Ultra Small Amount Funnel





Ideal for Small Batches: Process materials with as little as 10 grams of product — perfect for laboratory development and pilot projects.
No Residuals: Almost no product remains in the equipment, making it an excellent high yield small amount option.

Software: Design of Experiments (DoE)
Ease of Use: The funnel seamlessly integrates with the compaction unit of the Mini-Pactor, providing the same superior performance you would find in a full scale production machine.


Efficient DoE Implementation: Design of Experiments is the fastest and most cost-efficient way to create effective experiments. Tap into the power of DoE without the long learning curve.
Built-in Process Support: This goes beyond ordinary DoE software. It guides you on how to make optimal experimental choices, skipping impossible settings to save product and time.


Complete Guidance: From parameterization to execution, the software provides step-by-step instruction and support.


This first Eurolab of the year has several new areas of focus. We have a training section; a response to feedback from readers. It is clear that the bio-engineering sector requires cohesive collaboration between industry and education and that there is considerable work being done in this area. As such, it makes sense for us to provide information on this. We are also running a ‘Focus’ section, a standalone piece looking at a key topic. On pages 8-11 we provide an industry response to a report released by the UK’s House of Lords in late 2024 stating that the UK’s bioengineering sector needs improved training, investment and regulation. We provide views from the industry on how the UK compares with its international competitors as well as how the report’s recommendations might be implemented.
The cover story A clean up operation (page 20) looks at a series of new cleanroom products from Netherlands-based company Safe-T as well as the ISO requirements that such products need to meet. As usual, this issue features several articles on artificial intelligence. Of particular interest is a new platform from Telesis Bio explored in Life from a lab on page 18. The platform, called Gibson Sola, uses AI and computational technology to develop new biologics in a lab overnight.
Other articles of interest will the piece from Restek on dual-bed cartridges with filter aid (page 38); and CN Bio’s always innovative Organ on a chip work, explored in Data translation (page 28). This looks at how in-vitro to in-vivo translatability (IVIVT) of preclinical data is improved with the technology.
Nicola Brittain Editor

18
An overview of global news for scientists and lab technicians
FOCUS: THE UK’S BIOENGINEERING SECTOR
View from the industry Exploring recommended changes to the UK’s regulation, training, and investment environment ANALYTICAL AND LAB EQUIPMENT
Temperature tips How robust temperature control increases efficiency
Reduced pipette waste
Mitigating the problem of single-use pipette tips
Qualifying instruments
Using a continuous digital flow meter with liquid chromatography instruments
Life in a lab
The creation of in-house biologics goes mainstream
20 A clean up operation
A product suite that will help maintain clean room standards MICROSCOPY 24 Focus on sustainability
How electron microscopy can help combat climate change 20

can help avoid tablet production issues
Visualising human thought
Exploring the boom in brain-computer interfaces

PUBLISHER
Jerry Ramsdale
EDITOR
Nicola Brittain nbrittain@setform.com
STAFF WRITER
Jake Holmes jholmes@setform.com
DESIGN – Dan Bennett, Jill Harris
HEAD OF PRODUCTION
Luke Wikner production@setform.com
BUSINESS MANAGERS
John Abey | Darren Ringer
ADVERTISEMENT EXECUTIVES
Paul Maher, Iain Fletcher, Peter King, Adam Croft, Marina Grant, David Pattison
e advertising@setform.com
CONTACT US...
t +44 (0) 207 253 2545
e mail@setform.com
Polarisation resolved ramen analyses
AND SKILLS
The case for fair access How to make technical career progression fair
show for geneticists

Setform’s international magazine for scientists is published twice annually and distributed to senior professionals throughout the world. Other titles in the company portfolio focus on Process, Design, Transport, Oil & Gas, Energy and Mining.
The publishers do not sponsor or otherwise support any substance or service advertised or mentioned in this book; nor is the publisher responsible for the accuracy of any statement in this publication. ©2025. The entire content of this publication is protected by copyright, full details of which are available from the publishers. All rights reserved. No part of this publication may be reproduced, stored in a retrieval system, or transmitted in any form or by any means, electronic, mechanical, photocopying, recording or otherwise, without the prior permission of the copyright owner.
Setform Limited | 6 Brownlow Mews, London, WC1N 2LD, United Kingdom





President Trump has revoked former President Biden’s September 2022 EO 14081 order, “Advancing Biotechnology and Biomanufacturing Innovation for a Sustainable, Safe, and Secure American Bioeconomy”. The current president has said it: “funnelled Federal resources into radical biotech and biomanufacturing initiatives under the guise of environmental policy.”
The original initiative offered concrete plans to accelerate biotechnology innovation and grow the US bioeconomy across sectors including health, agriculture, and energy with a view to maintaining competitiveness in the global bioeconomy. It also pledged to collect genomic and multiomic information to “drive advances in health, climate, energy, food, agriculture and bioeconomy-related research and development as well as to “set forth a plan to fill any data gaps and make new and existing public data findable, accessible, interoperable, and reusable in ways that are standardised, secure, and transparent.” Commentators have said that revoking this order is likely to alter the public health data landscape considerably.

Global not-for-profit organisation,
The Pistoia Alliance, is launching the next phase of its project to measure and reduce the carbon footprint of clinical trials. The initiative will assess the environmental impact of digital trial delivery methods (eConsent, decentralised clinical trials (DCT)) and digital health solutions (devices and applications), compared with traditional, paper-based approaches. By closing a critical gap in the understanding of whether digital technologies are more sustainable, the project will establish a standardised methodology for evaluating the use of digital tools in clinical trials. To further support this effort, the Alliance is also launching a new whitepaper that explores the broader sustainability challenges in pharmaceutical R&D and the need for better measurement frameworks to drive meaningful change.
“The life-sciences industry is under increasing pressure to reduce its environmental impact, and clinical trials are a significant contributor. As CROs and sponsors embrace digital technologies, it is critical to understand whether these innovations are genuinely more sustainable than traditional methods,” explains Thierry Escudier, portfolio lead at the Pistoia Alliance.
The healthcare sector contributes approximately 5% of global greenhouse gas emissions and clinical trials are a significant part of this, producing approximately 100 million tonnes of carbon dioxide, equivalent to the annual carbon footprint of Belgium. These emissions stem from all activities performed to run clinical trials at pharmaceutical companies’ facilities and hospital sites.

Synthetic biology company Asimov, and Lotte Biologics, a global CDMO, have forged a strategic partnership focused on accelerating cell-line development and scaling to GMP manufacturing, having demonstrated a successful scale-up in operations.
This collaboration combines Asimov’s advanced CHO Edge cell line development platform with Lotte Biologics’ large-scale manufacturing services, significantly increasing efficiency and speed from development to production for therapeutic developers across the world, according to Asimov.
Alec Nielsen, Asimov co-founder and CEO, said: “We’re delighted
to be directly integrating with Lotte Biologics’ established manufacturing capabilities, meaning our customers can now transition seamlessly from cell-line development to large-scale GMP production to drastically shorten their development cycles.”
James Park, Lotte Biologics CEO, said: “We believe this agreement will unlock the full potential of both companies’ strengths. By combining Asimov’s impressive technology with Lotte Biologics’ manufacturing excellence, we plan to expland our customer base as well as drive innovation for the biopharmaceutical industry.


Lab informatics platform, Sapio Sciences, has integrated Nvidia’s BioNeMe platform into its own solution. This brings AI-driven computational drug discovery directly into the Sapio Electronic Lab Notebook (ELN), helping to streamline workflows and improve decisionmaking in drug discovery. With the BioNeMo platform, researchers can accelerate drug discovery by leveraging science-specific AI frameworks, pre-trained models, and generative AI tools to streamline the identification of potential drug candidates and improve target selection accuracy. Nvidia’s BioNeMo provides scientists with a framework

for training and deploying large biomolecular language models at supercomputing scale.
The integration of BioNeMo into the Sapio Platform provides scientists with embedded in silico tools (meaning those performed on a computer), enabling them to, for example, generate novel candidate molecules early in the research process to test their docking with a target protein. With AI-driven molecular simulations available within a single, unified workflow, researchers can streamline their processes, enhance innovation, and accelerate the transition from discovery to development.

Following the launch of the UK government’s greenpaper ‘Invest 2035’ and consultation in November last year, the UK’s biotechnology sector is anticipating an industrial strategy and new sector plans focused on growth to be published alongside the government’s spending review in Spring 2025. A statutory, permanent, and independent Industrial Strategy Council will be established with the view that the strategy is informed by a broad and high-quality evidence base. The UK’s BioIndustry Association (BIA) provided a lengthy response at the time, arguing that the strategy should: “Boost existing partnership working structures and policy; ensure focus is maintained on the key sub sectors and technologies in life science; address the key barriers to growth (it lists these in the response); and create the right conditions for increased investment.” The government has said its strategy is unreservedly pro-business, and will engage on complex issues that are barriers to investment including: skills; recruitment of international talent; data; research and development; technology adoption; access to finance, competition and regulation. For more on the UK government’s strategy for the sector read Focus: The UK’s bioengineering industrypages 8 to 12.


In this five-page overview, Eurolab looks at how the UK’s bioengineering industry might take advantage of a ‘small and closing’ window of opportunity to remain internationally competitive
Areport called ‘Don’t Fail to Scale: Seizing the opportunities of engineering biology’, released by the Lords’ Science and Technology Committee in December 2024, has said that the UK must take much greater risks to boost UK scientific innovation.
The result of an eight-month inquiry, the report states that the UK has already lost its once enviable global position in engineering biology and that it is in “severe” danger of falling further behind without “urgent action”. Without such action, the Lords’ report predicts that the UK will be trapped in a “doom loop” where foreign competitors leapfrog or exploit British breakthroughs.
The report also says there is a “small and closing” window of opportunity for the UK to reverse this pattern and reassert its global scientific position. The Committee called for action in seven key areas: strategy, skills, regulation, infrastructure, investment, adoption and governance.
In this five-page special feautre Eurolab sought a response to these recommendations from organisations in the field - policy and training trade body IchemE, The UK Institute for
Technical Skills and Strategy, and biotechnology company Amsbio.
When comparing the UK with other countries, IChemE head of policy and impact Duncan Lugton says: “until quite recently the US was the obvious big competitor in terms of access to capital, their positive regulatory and incentives regime as well as a highly skilled workforce”. But, he added, “things are a little bit less certain currently”. For example, last month, President Donald Trump revoked ex President Biden’s Executive Order 14081 “Advancing Biotechnology and Biomanufacturing Innovation for a Sustainable, Safe, and Secure American Bioeconomy,” originally issued on September 12, 2022.
The order had been intended to advance engineering biotechnology and biomanufacturing towards innovative solutions in health, climate change, energy, food security, agriculture, supply chain resilience, and more. Several commentators have argued that this decision is likely to have far-reaching consequences for the US biotech industry.
Lugton explains: “As a result of such changes, some countries like Denmark
are coming up with schemes to attract skilled workers that are leaving the US. “There is evidence that other parts of the world are seeing this as an opportunity,” he adds.
The report recommended that the government offers incentives to firms to invest in innovative bio-tech companies and products; as well as ensure that engineering biology is central to its industrial strategy. It also suggested that the UK government recommit to its £2 billion funding target over 10 years for research and development, this would ensure stable funding for laboratories.
The aim is to ensure UK scientists and technology companies can tackle global challenges and remain a world leader in the engineering biology sector.
“The Committee said that without urgent action across the key areas set out in the report, the “UK is at severe risk of losing the potential benefits of a engineering biology sector that can compete on the world stage”.
For more information read: https://publications.parliament. uk/pa/ld5901/ldselect/ ldsctech/55/55.pdf

Does the industry agree with the Committee’s findings? In this Q&A, Eurolab caught up with Alex Sim CEO of UK-based biotechnology company Amsbio for his insights
PLEASE GIVE ME A BRIEF OVERVIEW OF YOUR COMPANY AND ITS AREA OF EXPERTISE
AMS Biotechnology (Amsbio) is headquartered in Abingdon in the UK but is now owned by the Europa Biosite group of companies. The company leads in the supply of high-quality reagents and tools for life-sciences research specialising in innovative cellculture solutions, immunological reagents, and emerging technologies that support areas such as cell therapy and precision medicine.
DO YOU AGREE THAT THE UK IS FALLING BEHIND IN TERMS OF SCIENTIFIC INNOVATION AND HOW HOW DO YOU PREVENT FOREIGN COMPETITORS LEAPFROGGING YOUR TECHNOLOGY OR EXPLOITING YOUR BREAKTHROUGHS?
We agree that that the UK is currently falling behind in scientific innovation; a trend partially driven by factors such as Brexit and the migration of top scientists back to Europe as a result.
However, life sciences is a global endeavour. The focus should not be solely on protecting British breakthroughs from being ‘leapfrogged’ by foreign competitors; instead, it should be on investing in our own internal innovation and collaboration internationally. The real measure of success lies not in national borders but in engaging with the best global practices.
THE REPORT SAID THAT THE UK SHOULD IMPROVE SKILLS AND REGULATION AND DEVELOP A STRATEGY - DO YOU AGREE, AND WHAT WOULD YOU LIKE TO SEE IN A NATIONAL SCIENTIFIC STRATEGY?
A cohesive national scientific strategy would provide clear, top-down support that directly aligns research priorities with industry needs. Such a strategy could bridge the gap between academic discovery and commercial application by streamlining funding and providing a hub for innovation.
For example, in the UK, a promising reagent might be informally shared among colleagues, in the US, similar innovations often lead directly to the formation of start-up companies. This demonstrates the benefits of a well-co-
ordinated strategy that fosters an entrepreneurial culture.
One significant issue is the current model for universitybased startups, where a substantial portion of grant funding, which can be up to 40%, is allocated to university overheads. This can limit the funds available for actual research and delay the transition of innovative ideas to market. In addition, many universities will expect high royalties, some of up to 30%, which makes it much harder to be profitable and invest in growth.
A consolidated national strategy that boosted funding for high-priority sectors within biotech such as MicroPhysiological Systems (MPS) would help bridge this gap by offering larger, more sustained investment streams. Moreover, adopting international best practices, such as those seen in Switzerland, where focused investments in key sectors drive rapid progress, would help create a more predictable and supportive environment. This strategic focus would enable the UK to better harness its intellectual capital, accelerate technology transfer, and maintain competitiveness on the global stage.
While the UK’s regulatory framework is essential for ensuring safety and efficacy, it can sometimes create practical challenges that slow down innovation. A careful balance is needed between maintaining necessary regulations, for example in cell therapy, while facilitating innovation.
In addition, there are logistical and infrastructural barriers to overcome. For example, GDPR restrictions have, at times, complicated routine operational tasks like shipment notifications from European partners.
There is a pressing need for improved physical infrastructure, such as collaborative research hubs and incubators, that can more seamlessly bridge the gap between academic research and commercial ventures. Streamlining these regulatory and infrastructural elements would reduce delays and operational costs while preserving the high standards that are vital to the lifesciences sector.
A consolidated national strategy that aimed to boost funding for high-priority sectors within biotech such as MicroPhysiological Systems (MPS) would address financing issues by offering larger, more sustained investment streams

Amsbio has successfully leveraged several funding streams, including UK Innovate and EuroStar Grants, to support early-stage research and product development. However, these are much smaller amounts than you can access in the US, which serves as the best benchmark for supporting life science and technological innovation. For example, for a US-based company, a small business innovation research (SBIR) grant in the US might begin at around $300,000 with a subsequent phase offering a minimum of US$1m: levels of funding that are just not available in the UK.
This disparity in funding has tangible impacts on the growth trajectories of companies. A notable example is Solexa, a UK-based company founded in 1998 by University of Cambridge scientists. Solexa developed a groundbreaking genome-sequencing technology but faced limitations within the UK funding environment. In 2007, Solexa was acquired by the US company Illumina for approximately US$600m. Post-acquisition, Illumina leveraged the more robust US funding landscape to further develop and commercialise Solexa’s technology, establishing Illumina as a global leader in the field.
For an extended version of this article click here.


Saskia Henn looks at the skills gaps in the
engineering industry
TUK’s chemical and biological
and asks how they might be filled
raining in the UK’s engineering biology sector is something that the UK must urgently develop to avoiding falling behind other countries.
Currently, there is a shortage of professionals with robust training in engineering biology. There are several reasons for this, including the fundamental challenge that engineering biology crosses two research councils.
Both the Biotechnology and Biological Sciences and Engineering & Physical Sciences Research Councils are responsible for providing funding for grants, post-graduate degrees, scientific research institutes and university research departments.
The structural split in funding breeds uncertainty about which research council assists what organisations, and what form that assistance takes.
While challenges lie in the blueprints of the structure built to support
it, the problems with the training infrastructure extend far beyond that.
Many scientists reportedly struggle to translate their academic work into useful products ready to be marketed and sold. It is rare for a biology engineer to understand regulations and intellectual property, for example, because the opportunities for academics to learn about these topics are so few.
Members of the Institution of Chemical Engineers (IChemE), a community of chemical, biochemical and process engineers have noticed this.
IChemE head of policy and impact, Duncan Lugton, said: “We often see challenges for people who are really good at all the things they’ve trained for as an academic - getting those ideas, working in the lab, writing the grant proposals - but when they have to dive into some of the other kinds of skills, that are required to scale things up,” he continues, “this is quite a different set of skills, and there can often be a gap.”
Engaging with commercial realities at an earlier stage could help scientists increase the likelihood that their work move from pipette to product.
Another organisation that has observed similar challenges is the UK Institute for Technical Skills and Strategy (ITSS) a programme supporting organisations and employers of technicians to strengthen their technical workforce.
ITSS director Kelly Vere also suggests that incorporating commercial aspects into everyday laboratory education could help the UK with its scale-up problem by forging new routes forward.
“Employers and funders should prioritise retention strategies for technical professionals that include enhanced career progression pathways,” says Vere. “Recognising the overlap of technical and academic roles is key to creating new opportunities and ultimately a sustainable workforce.”
Enriching existing PhD programmes and offering more post-graduate learning opportunities are two more
ways to accomplish this, as there are currently only two doctorate training centres in the UK.
‘A-year-in-the-industry’-style programme could also provide opportunities for universities to collaborate with start-ups, smallto-medium enterprises and larger companies. With this type of education, academics are exposed early on to the inevitable commercial requirements they will bump up against in the laboratory.
Other aspects of training that require urgent attention are programmes below and beyond PhD level. Many technical positions do not require a PhD, but opportunities at earlier stages of university in the UK are lacking.
“We want to see the government prioritise chemical, biological and process engineering education and training at all levels, including things like significant expansions in technical apprenticeship, undergraduate, postgraduate and postdoctoral routes,” says Lugton.
While an aging technical workforce means that many colleagues are retiring, there are also plenty of experienced workers ready to learn new commercial skills on top of the technical skills they already have.
“It’s not just about growing new chemical engineers or whoever else in the workforce. It’s also about recognising that there are lots of people already in the workforce who could step into these roles with appropriate training, and I think that’s something that we really think the government should support,” says Lugton.

Training programmes below PHD level also require urgent attention
Re-skilling is a valuable resource to obtain skilled workers already in the UK and familiar with the industry.
“Employers of technicians would significantly benefit from investing in technician-specific training, including technical skills aligned with critical technologies and professional development programmes that are designed for the unique roles of technicians,” says Vere.
Re-skilling staff will support the scale-up infrastructure that the UK desperately needs to prevent talent from leaving the country to find better opportunities abroad.

The Lords report touches on several areas of training in the UK that are most needed and some organisations are hopeful that the document is an acknowledgement from the government that scaling up young companies and developing commercial sense and technical skills must now be a priority.
“The government clearly understands that this is important,” says Lugton. “We just want to see more specifics regarding these plans as they get developed, and to help play a part in refining and make a success of them.”
The cannabis industry has seen exponential growth in recent years, driven by the increasing acceptance of cannabis for both medical and recreational use.
As the industry evolves, the need for precise temperature control in various stages of cannabis production has become paramount. This article explores the advanced temperature control techniques employed by the cannabis industry, highlighting the role of Peter Huber Kältemaschinenbau SE equipment in ensuring product quality and consistency.
Temperature control is a fundamental aspect that influences several stages of cannabis production, including cultivation, extraction, and storage. Maintaining optimal temperatures is paramount to preserving the potency and efficacy of cannabinoids, terpenes, and other valuable compounds inherent in the cannabis plant. Without precise temperature regulation, the integrity of these compounds could be compromised, leading to subpar product quality.
The extraction process is where temperature control is crucial. Various extraction methods, such as CO2, ethanol, and hydrocarbon extraction, require precise and reliable temperature regulation to achieve optimal results. Peter Huber Kältemaschinenbau SE’s Unistat

Peter Huber Kaltemaschinenbau SE’s Unistat range
systems provide the necessary temperature control for these processes. For instance, CO2 extraction involves supercritical CO2, which requires maintaining temperatures between -70°C and -30°C. The Unistat units, renowned for their responsive and precise temperature control, according to the company, ensure that the extraction process remains within the desired temperature range, resulting in high-quality and higher yields of cannabis extract.
Several innovative temperature control technologies have emerged to address the unique challenges of the cannabis industry. These include:
1. Dynamic and responsive temperature control solutions for perfect process control: The Unistat range from Huber offers dynamic and responsive temperature control systems that are ideal for cannabis production. These units enable precise temperature control with cooling capacities from 0.7 to 130 kW. Whether for cannabinoid extraction, distillation or crystallisation, Unistat
units ensure constant and reliable temperature control to optimise production conditions.
2. Chillers and immersion coolers: In addition to dynamic temperature control systems, Huber also offers classic chillers and immersion/ circulation thermostats. These products are versatile and suitable for vapour traps and smaller production systems. They ensure reliable temperature control and contribute to process efficiency.
As the cannabis industry continues to grow, the importance of dependable temperature control techniques cannot be overstated. Having a utility that maintains temperatures at which the efficiency of any temperature dependant stage in the process is at its peak. This increases the purity, the yields and reduces production times. Efficient, robust and reliable temperature control simply put, increases the profits to the producer of cannabis products.


Discarded single-use pipette tips create a staggering waste stream
The single-use pipette tip, an unavoidable consumable in modern biological and chemical research, presents a significant and growing global environmental challenge. While essential for precise liquid handling and preventing cross-contamination, their sheer volume generates a staggering waste stream. Estimates suggest billions of tips are discarded annually, contributing to plastic pollution and resource depletion.
The environmental impact extends beyond mere landfill accumulation. These tips, often made from petroleumbased polypropylene, require substantial energy for production. Furthermore, their disposal, particularly incineration, releases harmful greenhouse gases and potential toxins. The reliance on single-use items fosters a linear ‘takemake-dispose’ model, unsustainable in a resource-constrained world.
The sheer volume of discarded pipette tips contributes significantly to the global plastic waste crisis. As highlighted by sources such as the Babraham Institute, laboratory plastic waste is a very large contributor to the overall problem. Studies have shown that items like pipette-tip boxes make up a very large percentage of laboratory plastic waste.
This waste can persist for centuries, breaking down into microplastics that contaminate soil and water, posing risks to wildlife and potentially entering the human food chain.
Efforts to mitigate this impact are gaining momentum. Autoclaving and reusing tips, while feasible for some applications, raise concerns regarding accuracy and sterility. However, innovations in biodegradable and reusable pipette tips and packaging offer promising alternatives. Research into bioplastics derived from renewable resources, such as polylactic acid (PLA), presents a potential solution. Though challenges remain regarding cost and material properties, advancements in biopolymer technology are paving the way for more sustainable options.
Furthermore, implementing robust recycling programs within laboratories is crucial. Closed-loop systems, where used tips and packaging are collected, processed, and repurposed, can significantly reduce waste. Education and awareness campaigns are also vital to encourage responsible consumption and promote sustainable practices.
In the meantime, a shift towards a circular economy in laboratory consumables is imperative. This requires collaboration between researchers, manufacturers, and
policymakers to develop and implement sustainable solutions. This includes encouraging the development and adoption of reusable or biodegradable pipette tips and packaging as well as supporting manufacturers who prioritise sustainable production and packaging. As seen from Alpha Laboratories, there is a push to use recycled and recyclable materials in the production of the FastZAP pipette tips that are designed with a minimal amount of packaging while preserving product quality.
The environmental cost of scientific progress cannot be ignored. By embracing innovation and adopting responsible practices, the scientific community can minimise its environmental footprint and contribute to a more sustainable future.
U.S. Environmental Protection Agency. (n.d.). Sustainable Materials Management: NonHazardous Materials. Retrieved from epa.gov
The journey and impact of a pipette tipBabraham Institute: https://www.babraham.ac.uk/ blog/pipette-tips
Rizan, C., & Hankemeier, T. (2021). Towards sustainable analytical chemistry: A critical review on greening liquid chromatography. Analytical and Bioanalytical Chemistry, 413(16), 4065–4085. Arnott, J. T., & Pilon, L. (2020). Environmental life cycle assessment of single-use and reusable laboratory plasticware. Journal of Cleaner Production, 258, 120677.
For more information visit: www.alphalabs.co.uk/fastZap














Exploring the facilitated qualification of liquid chromatography instruments using a new continuous digital flow meter
Qualification procedures for liquid chromatography instruments (HPLC & UHPLC) are designed to ensure that the analysis instruments work correctly and thus generate consistent and valid analytical results. An incorrect flow rate will inevitably affect substance retention times and chromatographic peak area integration, which in turn influence the accuracy of quantitative results, especially if the flow rate is unstable.
Instrument qualification tests have been defined [1] by the European Network of Control Laboratories (GEON), which is coordinated by the European Directorate for the Quality of Medicines & HealthCare (EDQM). Laboratories accredited according to ISO/IEC 17025 are required to implement these quality assurance procedures, although others aiming to provide high quality products and services, can certainly also benefit from similar efforts to ensure that trustworthy analysis results are continuously generated. Similar guidelines have been issued [2] by the United States Pharmacopeia (USP) as part of its general chapter <1058> which currently is under revision.
The periodic checks mentioned in the equipment qualification guidelines for instrument modules (“Level III”) [1]

issued by GEON, include experiments to verify that the flow rate is accurate [1,3], together with practical examples of how data could be gathered. The assessments involve ensuring that the absolute flow rate is within a suggested ±5% of the set value for HPLC instruments, and within ±3% for UHPLC systems. The typical acceptance limit for flow rate precision has been set to ≤0.5% relative standard deviation (RSD) for these tests. In essence, this corresponds to the operational qualification (OQ) in the USP nomenclature [2].
Traditionally, the liquid flow rate
was measured by collecting the exit liquid while simultaneously recording the gathering time [3]. The collected liquid was then determined either volumetrically or gravimetrically, making these methods inherently manual and labour intensive. Previous digital liquid flow meters have mainly automated the volumetric measurement approach, and such devices have integration times ranging from tenths of seconds up to one minute at typical liquid chromatography flow rates (0.2 - 1 mL/min).


A more recent technology for determination of flow rate is thermal conductivity [4]. This non-invasive principle involves two temperature sensors on a quartz glass tube, with a heating element positioned in-between, as depicted in Figure 1. With a built-in algorithm that converts heat difference to flow rate using internally stored calibration data, devices based on this principle can determine flow rate with a high frequency. The Biotech Liquid Flow Meter is constructed on this principle and produced into a handy physical size (see Figure 2). This flow meter can deliver readings every 78 milliseconds, thereby enabling highresolution flow monitoring to detect variations and pulsating behaviour from pumps, as shown in Figure 3.
The specifications of this flow meter have been independently verified by a European accredited calibration laboratory using traceable standards. Their report concluded that the deviation from the reference value was below ±0.17% for all five tested flow rates within the range 0.15 to 5.0 mL/min. The uncertainty was determined to be 0.2% full scale deviations at the highest flow rate
but lower within the rest of the tested range. These tests verify that the Biotech Liquid Flow Meter match the specifications from the manufacturer while also fulfilling the requirements for operational qualification of HPLC & UHPLC equipment and other fluidic systems where the quality of the results depend on a reliable flow rate.
When used within the Advanced Pump Validation Kit, i.e., with a standardised and automated protocol for data collection and calculation, the Biotech Liquid Flow Meter will provide a full data set plus a report for qualification of HPLC & UHPLC equipment within 10 minutes. This validation test report contains information about the average flow rate and its deviation from the nominal flow of the pump, plus relative standard deviation from five independent determinations, and a traceable reference to the stored raw data file.
Unique to the Biotech Liquid Flow Meter with the Advanced Pump Validation Kit is that it provides an independent assessment of flow pulsation. This can be used as an additional quality parameter for
pumps to follow their wear and thus plan ahead for maintenance actions. The pulsation parameter is calculated as a relative max-min value within two minutes, which corresponds to how noise typically is defined and measured in analytical measurements including liquid chromatography.
REFERENCES:
[1] GEON Quality Management Document PA/ PH/OMCL (11) 04 R7 (2005) “Qualification of Equipment Annex 1: Qualification of Liquid Chromatography Equipment”, General European Network of Official Medicines Control Laboratories, Strasbourg, France.
[2] United States Pharmacopeia General Chapter <1058> (2017) “Analytical Instrument Qualification”, Unted States Pharmacopeial Convention, Rockwille, Maryland, USA.
[3] P. Uthaiwat, T. Leeudomwong, T. Sanponpute, “The comparison of flow rate calibration methods for high‑performance liquid chromatography (HPLC) pump”, Accreditation and Quality Assurance (2024) 29:205-214.
[4] Biotech Liquid Flow Meters, https:// biotechfluidics.com/products/sensors/biotechliquid-flowmeter/ (accessed 2025-03-10).
AUTHORS:
Dr. Tobias Jonsson, CEO, Diduco AB, Umeå, Sweden
Anders Grahn, Chairman & Founder, Biotech Fluidics AB, Onsala, Sweden

Almost all companies involved in biological or drug discovery are now using AI tools to design molecules, and a large cash injection into a recently developed platform from synthetic biology company Telesis Bio promises to significantly accelerate activity of this sort. The solution, a platform called Gibson Sola, has just received US$21m in funding from venture capitalist firm Northpond Ventures, and big hitter investment and consultancy firm Novalis Life Sciences. The injection will help to drive rapid
commericalisation of the platform. The platform uses AI to create biologics overnight, the result being faster more reliable and innovative solutions, according to the company. The products created will be for use in biologics, vaccine and cell therapy research and development. After an extensive development period, the platform was launched to all customers in January of 2025.
DNA and mRNA are critical raw materials that power therapeutic

research and molecular diagnostics, and demand for high-quality nucleic acids from researchers and scientists is large and growing rapidly. The platform will mean researchers do not have to rely on an often complicated external supply chain since it allows them to make DNA and mRNA overnight in their own labs using standard liquid handling equipment. The platform and software suite can be used to deploy automated on-site synthesis solutions for a variety of targets, molecules, as well as applications, from low- to highthroughput.





Telesis Bio describes its new Gibson SOLA platform as a ‘digital to biological converter’ that uploads sequences into proprietary software and provides a predictive success score that can be used to optimise sequences. DNA is then assembled in a mechanism that enriches for the correct molecule at each cycle and produces uniquely high-quality DNA that does not require further downstream purifi cation.
Sequences used for building the biologics are provided by the scientists, meaning they are in full control of the entire process. They can also use the resulting DNA or mRNA in any future experiments.
According to Eric Esser, chief executive of Telesis Bio, the product “allows customers to design a gene and make it in-house overnight, helping to feed their AI engine.” He continues: “The technology is fast, high-quality and fully automated, providing data that will fuel drug discovery and the ability to develop breakthrough therapies. It has also been designed to allow customers to take full control of their nucleic acid supply-chain, protect valuable intellectual property, and maintaining ownership of data and insights.
We fully expect this to have a signifi cant impact on future AI drug discovery processes and models.”
As stated, customers will be generating their own proprietary data and this can be used to gain insights and enhance future AI models. This is also a potential revenue stream for the research community.
Telesis Bio claims that the platform trains AI models 93% more quickly than if a researcher relies on outsourcing; it also creates molecules that may be very difficult for a service provider to manufacture.
Esser says: “Allowing DNA and mRNA creation in house and overnight puts control of what is being built with the researcher or scientist rather than their service provider. This marks a sea change in what was traditionally a very complicated and time consuming process.”
The funding was led by Novalis LifeSciences and Northpond Ventures and will take the form of a Purchase Agreement that provides for the sale and issuance of convertible preferred stock in two closings. The

initial tranche included the sale and issuance of approximately US$17m in shares of convertible stock of which US$8m was tied to cash infusion, and US$9m was related to conversion of outstanding debt into convertible stock. Subject to the determination of the company’s board of directors to affect the second tranche closing on or before March 6, 2026, the second tranche is expected to include the sale and issuance of US$4m in shares of convertible preferred stock.
Northpond Ventures is a multi-billion dollar science-driven venture capital firm based in the US. The firm is engaged in the academic ecosystem, having founded The Laboratory for Bioengineering Research and Innovation at Harvard’s Wyss Institute, The MIT-Northpond Program, and The Northpond Laboratories – Program for Research and Innovation at Stanford Medicine. Northpond Ventures has led or co-led over 60 financings since it was set up in 2018 and sits on the board of the vast majority of these businesses.

A new series of sleek cleaning products for clean rooms impress with their commitment to sustainability and efficiency
Cleaning is still the bane of many of our lives; and this isn’t just for people with full-time jobs, children, or a house with too much clutter. Most pharmaceutical and biotechnology companies must also maintain a controlled clean environment – in a clean room - if they are to prevent contamination during the production of drugs. Similarly, medical device manufacturers must ensure the sterility and safety of medical devices using similar standards, and semiconductor manufacturers must
protect their delicate silicon products from dust and static.
To qualify as a cleanroom, an area must meet rigid ISO 14644 standards, This protocol is made up of several sub elements including ISO’s 1 to 9. ISO 1 is the ‘cleanest’ class and ISO 9 is the ‘dirtiest’. Even as the ‘dirtiest’ class, the ISO 9 clean room environment is cleaner than a regular room.
The most common ISO clean room classes are ISO 7 and ISO 8. The Federal Standard 209 (FS 209E) equivalent for these ISO classes are Class 10,000 and Class 100, 000.
The ISO standards typically measure parameters such as airborne particle count; airflow velocity and uniformity testing to ensure that the air circulation carries away particles and contaminants; air pressure differential testing; temperature and humidity testing; and lighting and
noise levels. Proper documentation of all testing procedures, results, and any corrective actions taken is a crucial component of cleanroom certification. Creating innovative cleaning products for such an environment is therefore a considerable feat, one that has been met with aplomp by the engineering team at Safe-T, a division of the Netherlandsbased company i-Team.
The team hired a facility in Dublin last month to demonstrate its newly launched family of cleanroom solutions at an event called the Guardians Of The Cleanroom, The products had been rigorously tested in independent laboratories prior to launch to ensure compliance with the ISO cleanroom standards mentioned.
The products being demonstrated were the Safe-T-IMOP, a vertical scrubber dryer for cleanrooms and sticky mats (ISO 5-6); SafeT-VAC, a cordless vacuum cleaner (ISO 4-5); Safe-T-BOT 45, a robotic scrubber dryer (ISO 5). All products are battery powered and the absence of cables makes cleaning easier and reduces strain on operators, according to the company. The products are programmable and lightweight with ergonomic features.
The machines also operate







Overfill protection


Lightning-fast, one-button repeat dispensing of aliquots



Aliquot faster, aspirate safer, pipet smarter.
The most revolutionary serological pipet controller










Brings color into your lab!















mechanical scrubbing and Ultra-Low Particulate Air (ULPA 15) filtration, removing more embedded particles than manual methods and capturing over 99.999% of contaminants as small as 0.1 microns, according to Safe-T.
As Ryan McClymonds, global technical director explained during the demonstration, the products, bar the I-MOP, have already received GMP certification and the remaining product is due to be certified any time soon. These innovations help businesses keep contamination out of critical environments while “saving time, reducing costs, and addressing staff shortages,” he added.
Combining stringent floor cleaning ability, ergonomic design and efficient battery systems, these products will be distributed to industry sectors such as high-tech semiconductors, medical device manufacturers, healthcare, pharmaceuticals, and food production.
For more information about these products visit: www.I-team Global
The Safe-T products will be distributed by FM (Factory Manual) company Bidvest Noonan whose customer, globally renowned technology brand JLL, sought an advanced and specialised solution for its cleanrooms.
The Safe-T range was developed to meet the needs of the company which already operates world-class cleanrooms. To support its customer, JLL, Bidvest Noonan engaged cleaning products supplier Clenli Direct, who worked closely with the manufacturers i-Team Global to bring the range to market.
We are proud to be the first company to offer a suite of automated cleaning solutions specifically designed for cleanrooms. Cleanroom cleaning companies play a vital role in minimising downtime. Now we are providing them with superpowers to tackle contamination with efficiency and precision, reducing downtime and saving significant costs
Frank van de Ven, founder and CEO of i-team Global


the world of botanical extraction!





us at ICBC Berlin, Booth 414






Inspired by temperature
Consistent and accurate temperature control solutions for easy integration in extraction labs and distillation plants for the best results and highest yields.


Kate Vanderburgh, senior product specialist at Thermo Fisher Scientific, explains how electron microscopy (EM) drives material innovation to support low-carbon technologies and combat climate change
The advancement of materials is vital for developing low-carbon technologies. In renewable energy, semiconductors boost solar efficiency, while advanced composites improve wind turbine durability. Furthermore, in energy storage, breakthroughs in electrodes and electrolytes enhance battery performance, lifespan and stability. Electron microscopy (EM) plays a crucial role in these advancements, providing nanoscale resolution for detailed characterisation of material structures, interfaces and defects. This optimises properties such as conductivity, durability and catalytic efficiency, essential for energy storage and renewable energy systems.
Several technologies that are core to advancing sustainable progress reap the benefits of EM throughout their lifecycle.
For instance, EM drives advances in solar panel materials by revealing microscopic defects and grain boundary structures with subnanometer precision. In perovskite solar cells, EM uncovers variations in crystallinity and composition that affect charge transport and recombination. This precise insight allows researchers to optimise material formulations and processing methods, resulting in higher efficiency and improved device stability.
EM is indispensable throughout the entire lifecycle of battery materials. It enhances the lifespan of lithium-ion and solid-state batteries by identifying structural weaknesses at the nanoscale, detecting defects such as dendrite formation, which can cause short circuits, it also monitors chemical changes during charging. These insights help engineers develop more environmentally-friendly battery materials that support circular economy principles.
Hydrogen technology also benefits from EM’s capabilities. EM is used to analyse hydrogen storage alloys and fuel cell materials by revealing nanoscale structural features and elemental distributions critical for efficient hydrogen uptake and release. This information guides the optimisation of material design, leading to faster hydrogen absorption, improved storage capacity and enhanced long-term stability — key factors for scaling hydrogen-powered transport and renewable energy systems.

Developing advanced materials for low-carbon technologies requires precise structure and compositional analysis. However, modern materials — such as solid-state battery electrolytes and hydrogen storage alloys — present challenges that traditional EM methods struggle to address.
Conventional scanning electron microscopy (SEM) provides highresolution imaging of material surfaces, revealing grain boundaries and nanoscale defects. Meanwhile, energy dispersive X-ray spectroscopy (EDS) analyses elemental composition.
In traditional workflows, these techniques require sequential analysis, with EDS performed after, or instead of, imaging, often under different conditions. This can lead to inconsistencies, making it difficult to link structure to composition. Furthermore, emerging sustainable materials usually have complex, heterogeneous compositions in which subtle elemental variations impact performance and longevity.
Thermo Fisher’s ChemiSEM presents a single, streamlined solution that integrates SEM imaging and EDS analysis into one user interface. This not only enables faster result times and live structural and compositional
analysis but also provides accurate quantification, complete with live peak deconvolution and automated removal of sum and escape peak artifacts.
As an integrated data management platform combining advanced elemental analysis with real-time electron imaging, ChemiPhase within ChemiSEM enables the discovery of material phases through advanced statistical analysis allowing users to perform SEM and EDS analysis simultaneously, reducing response times and minimising redundancies. Multiple different types of analysis can be performed in ChemiSEM, including point and region analysis, line scans, gross count mapping, quantitative mapping and phase mapping.
Solar energy is a critical form of renewable energy and is primarily harvested by photovoltaics which convert sunlight into electricity. Materials research and characterisation is at the forefront of making current solar cell technology cheaper, more efficient and more reliable. EM is an important technique to view photovoltaic materials at micro and nanoscales to examine the material structure and composition. Figure 1 shows an Ag/Zn Si photovoltaic simultaneously imaged
with four different detectors on a Thermo Fisher Apreo ChemiSEM SEM. At first inspection, there appeared to be differences in material structure and compositional contrast throughout the sample surface. ChemiSEM made it possible to deconvolute these differences owing to topography versus chemical structure with a click of the ChemiSEM colour wheel and spectra buttons and without having to change any imaging conditions. Figure 2 illustrates a ChemiSEM image of the A) Ag/Zn Si photovoltaic and individual quantitative elemental maps of B) silver (blue), C) zinc (pink), and d) silicon (green). Being able to identify the elemental distribution helps to better understand material properties to progress photovoltaic research for a cleaner energy future.
Electron microscopy is proving indispensable not only for earlystage research and development but throughout the entire lifecycle of sustainable materials. Such comprehensive capabilities are critical as nations work to meet the ambitious climate targets set forth in the upcoming 2026–2031 NDC deadlines, ultimately supporting the transition to a sustainable, low-carbon future.




Global leader in capsule manufacturing, ACG Capsules, has launched the first fully vegan printed capsules, according to the company, marking a significant advancement in the pharmaceutical and nutraceutical industries.
Made from plant-based polymers like Hydroxypropyl Methylcellulose (HPMC), ACG’s vegan printed capsules are certified by Vegan Action and The Vegetarian Society. Every aspect of the capsules —from shell to print— meets stringent vegan standards and supports the growing demand for transparency, sustainability, and cruelty-free options in medications and dietary supplements.
• 100% vegan composition: Entirely free from animal-derived ingredients.
• Sustainability focus: Made with plant-based materials, ACG’s vegan capsules reduce reliance on synthetic chemicals, supporting cleaner production.
• Enhanced transparency: The vegan composition addresses consumer demand for clear, ethical product sourcing.
• Market differentiation: Provides a



ACG’s capsules are certified by the Vegan Society


A cellulose product that sets new tablet
competitive edge for nutraceutical brands in a growing market segment.
Dr. Subhashis Chakraborty, head of global product management, ACG Capsules said: “At ACG, we are committed to delivering innovations that align with ethical and sustainability principles.” She continued: “our vegan printed capsules empower brands to meet the rising demand for animal-free, eco-conscious solutions, fostering greater transparency and trust among consumers. As the first company to introduce vegan printed capsules, ACG is setting a new benchmark for innovation, reinforcing its commitment to consumer well-being and sustainable progress in healthcare.”
ACG’s vegan printed capsules are available in three ink colour options— green, black, and brown—that can be applied across the entire HPMC capsule portfolio, This allows brands to customise their messaging while adhering to ethical and sustainable standards.
More generally Dr Chakraborty, general manager, head - global product management, ACG Capsules explained that he expected advances in manufacturing technology and

polymer science to revolutions the capsule industry, driving the widespread adoption of cellulosebased capsules. These innovations address raw material concerns, enhance API release and stability, and offer significant advantages to formulators. As the limitations of gelatine become increasingly evident, scientists are leveraging modern technologies to optimise product development and adapt to shifting market demands.
The adoption of cellulose capsules continues to grow significantly. While costs may pose challenges, the industry’s focus on rapid market entry and rapid development underscores the advantages of vegetarian alternatives, which are already beginning to benefit from economies of scale and these are likely to increase over time.
Global supply chain stability and environmental sustainability remain top priorities for tablet manufacturers. Coupled with instability in the capsule manufacturing market, it is important that such companies broaden their supply base. For the healthcare industry, securing a sustainable capsule supply has never been more critical.




Fuel therapeutic innovation with TriLink’s industry-leading nucleic acid products, available in Europe now through VWR

CleanCap® cap analogs – Achieve over 95% capping efficiency and high protein expression using a streamlined manufacturing process
IVT enzymes – Discover IVT enzymes, including CleanScribe™ RNA Polymerase for up to 85% dsRNA reduction without compromising yield, quality, or purity




Through a new partnership with VWR, the delivery channel of Avantor, TriLink Biotechnologies catalog of nucleic acid technologies and capping reagents are now more accessible to customers in Europe. Explore a comprehensive series of products, including:
Catalog mRNAs – Choose from three unique designs over 10 different genes, all capped with a CleanCap® cap analog
Modified and unmodified NTPs – Over 150 modified and unmodified nucleotides offered as catalog and custom options
See how TriLink’s cutting-edge offerings can advance your work, from discovery-stage research to commercial manufacturing.
Explore our full catalog of products here.
How in-vitro to in-vivo translatability (IVIVT) of preclinical data is improved with Organ-on-a-chip technology
Following the passing of the FDA’s Modernisation Act
2.0 in 2022, the use of New Approach Methodologies (NAMs), including Organ-on-aChip (OOC), is now supported and encouraged by the world’s largest regulator for evaluating drug safety and effectiveness in place of animal testing, where appropriate. Despite this progress, replacing animals in safety testing is challenging and likely to be slow, since animal models provide many organ-specific readouts that are not fully reproductible in vitro
However, there are contexts of use where OOC data can be used to supplement animal data and improve safety risk assessments through better informed decisions about humanrelevant safety – especially for the liver. Most medications are metabolised in the liver, which makes it susceptible to adverse drug reactions. A publication by Singh et al., 20251 highlights that
The PhysioMimix
Single-organ System and Multi-chip
Liver 12 plates
55 medications were approved by the US FDA in 2023, with 22 (40%) having evidence of liver toxicity in the drug label or clinical trial results. So, for some, why was DILI only identified in human studies?
Two retrospective reviews found the positive concordance between liver toxicity in animal tests and clinical trials was 55% (Olson et al., 2000)2 and 33% (rats), 27% (dogs), and 50% (monkeys) (Monticello et al., 2017)3. The main reason relates to interspecies differences in drug disposition, however, there are other contributing factors as reviewed by Taylor et al., 20254. This problem is further exacerbated by newer humanspecific drug modalities for which animal testing is less suited. These reasons necessitate the need for pre-clinical toolbox modernisation with NAMs, including OOC, to deliver improved in-vitro to in-vivo translatability (IVIVT).

Human liver-on-a-chip models are utilised to predict and gain a mechanistic understanding of drug induced liver injury (DILI). Their enhanced human relevance provides a means to overcome the limitations of animal models, which can miss some instances of idiosyncratic DILI, plus they provide a viable path forward for new drug modalities. One approach used by OOC vendors to prove their enhanced translatability is by studying flawed drugs that made it to market. However, unless unsuited, preclinical testing involves testing in animal models. Data discrepancies between human in-vitro and animal in-vivo studies make the final assessment of drug safety in humans challenging. So, do we need to take a step back and more effectively translate data

Most medications are metabolised in the liver, which makes it susceptible to adverse drug reactions




between in-vitro animals and in-vivo animal studies to address this gap?
In preclinical testing, the drug developer is responsible for the choice of in-vivo species. Factors including the drug target and how closely the animal species mimics human responses influence decision-making, as does previous experience from past trials.
International guidelines specify the use of at least one rodent and one non-rodent species. Rats and dogs are most frequently used in toxicology testing, particularly for small molecules, with non-human primates (NHPs) common for newer drug modalities. All pre-clinical data needs to be reported in regulatory filings.

to flag interspecies differences early, better inform in-vivo study design and support go/no decision-making. Insights from these advanced in-vitromodels help to prevent drugs that are potentially safe in humans from being dropped unnecessarily from the pipeline and de-risk those that weren’t adequately flagged by animals from progressing into preclinical testing.
Sitaxentan, a pulmonary hypertension medication, was removed from the market in 2010 owing to concerns over liver toxicity. A review by Owen et al., 20125 examined preclinical animal species studies where the severity of the toxicity was missed. The authors highlighted that it was not a deficiency in the preclinical package that resulted in the missed toxicity and translational errors; rather, it was a shortcoming of the preclinical species to predict human outcomes, or the mechanistic details of toxicity.
To
and Multi-chip Liver 12 plates, with drugs that have known interspecies differences, including sitaxentan. Leveraging clinical markers, including alanine aminotransferase/ aspartate aminotransferase (ALT/AST), this method provides the ability to rank order drugs by safety risk across commonly used species before the preclinical phase.
The approach also supports 3Rs objectives and ethical considerations, including the length of testing required, cost, and availability of models (especially for NHPs). It facilitates the responsible use of animals as hundreds to thousands of in-vitro tests can be performed per donor and their insights safeguard future animal use.
CB Bio continues to qualify these models to further its understanding of the IVIVT potential of these. Sign up to the company’s newsletter via the website below to receive data comparisons when published.

QR Code: details of the technology here
1. doi.org/10.1007/s40264-025-01514-z
2. doi:10.1006/rtph.2000.1399
3. doi:10.1016/j.taap.2017.09.006
4. doi.org/10.3389/fddsv.2025.1536756
5. doi.org/10.1016/j.yrtph.2012.05.017
Confocal image of human liver tissue. Nuclei (blue), albumin (yellow), C-reactive protein (green) and actin (red) For more information visit: https://cn-bio.com
For this reason, CN Bio has been developing preclinical rat and dog liveron-a-chip models as translational tools. These tools enable comparative studies
To demonstrate the translatability of cross-species DILI assays, we have been dosing human and crossspecies models, cultured using the PhysioMimix Single-organ System

Figure 1: Promising kinase targets and converging pathways in neurodegenerative diseases. Figure source: https://doi.org/10.3389/fnagi.2020.00242
Here, biotechnology company Sino Biological explores kinase inhibitors and how they promise impressive therapeutics for neurodegenerative diseases
Neurodegenerative diseases like Alzheimer’s (AD), Parkinson’s (PD), and amyotrophic lateral sclerosis (ALS) suffer from a scarcity of effective treatments. Current therapies primarily provide symptomatic relief but do not address the underlying pathology, failing to slow or halt disease progression. This underscores the urgent need to identify new therapeutic targets relevant to the pathology of these conditions. Kinases represent highly tractable drug targets, with kinase inhibitors achieving
significant success, particularly in oncology. However, their potential in neurodegenerative diseases remains largely unexplored, presenting a promising avenue for future research and therapeutic development.
The rationale for targeting kinases in central nervous system (CNS) drug discovery is based on the understanding that phosphorylation, catalysed by kinases, plays a pivotal role in regulating many cellular processes, and that at least a number of phosphorylation processes may become aberrant in disease (Figure 1). Over the past decade, there
has been an increasing interest in the therapeutic potential of brain penetrant kinase inhibitors for neurodegenerative diseases. The development of kinase inhibitors, such as glycogen synthase kinase-3β (GSK3β) inhibitors for AD, leucine-rich repeat kinase 2 (LRRK2) inhibitors for PD, and mitogen-activated protein kinase kinase kinase kinase (MAP4K) inhibitors for ALS, has shown promise, though challenges like specificity, blood-brain barrier penetration, and drug resistance remain.
Kinases are integral to the regulation of signaling pathways in the brain, and alterations in their function are implicated in neurodegeneration. In neurodegenerative diseases, certain kinases are often overactive or overexpressed in specific brain regions. This dysregulation frequently drives the hyperphosphorylation of proteins that are prone to aggregation, such as tau in AD, α-synuclein in PD, and TDP-43 in ALS. Moreover, aberrant kinase signaling can also induce other diseasepromoting phenotypes, including






›
›
›
›
›







Figure 2: Representative pathways of mitochondrial dysfunction implicated in the pathophysiology of PD. The listed proteins contribute pathologically to the different pathways. Figure source: https://doi.org/10.1007/s11910-018-0829-3
neuroinflammation and neuronal death. Conversely, loss-of-function in kinases has emerged as a critical genetic factor and a major contributor to the development of several neurodegenerative diseases.
The two main pathological hallmarks of AD are the extracellular amyloid beta (Aβ) plaques, which result from the accumulation of Aβ, and the intracellular neurofibrillary tangles (NFTs), composed of abnormally phosphorylated tau. Elevated GSK-3β activity is directly linked to tau hyperphosphorylation and increased production, contributing to molecular pathologies, neuronal damage, and cognitive decline in AD. Fyn also represents a compelling therapeutic target for AD, as it is activated by Aβ through the cellular prion protein (PrPC) and also interacts
with tau, uniquely bridging the two key pathologies in AD.
Pathologically, PD is characterised by the progressive loss of dopaminergic (DA) neurons in the substantia nigra pars compacta (SNpc) and the accumulation of intracellular α-synuclein in the form of Lewy-body. Mutations in LRRK2 are the most common genetic cause of familial PD and represent a significant risk factor for sporadic PD. Mutations in PTENinduced kinase 1 (PINK1) are also associated with familial PD. Extensive evidence suggests that mitochondrial dysfunction is a central factor in PD pathophysiology (Figure 2). Mutations in autosomal dominant LRRK2 and autosomal recessive PINK1 are directly linked to mitochondrial dysfunction, highlighting their critical roles in the pathogenesis of PD.
ALS features gradual loss of muscle controls due to degeneration of motor neurons. MAP4K4, a member of the STE20 family, has been identified as a key regulator of motor neuron degeneration in ALS. Inhibition of MAP4K4 can facilitate neuron survival and prevent neurite degeneration under conditions of exogenous or endogenous stress, suggesting that MAP4K4 is a druggable target for ALS therapeutics.
In AD: GSK-3β inhibitors have been extensively studied. GSK-3β is involved in tau hyperphosphorylation and Aβ formation, both of which are key pathological features of AD.
Derive mechanistic signatures of human hepatotoxicity including complex, latent & immune-related effects with the PhysioMimix® DILI assay kit: Human 24
Effortless adoption
Easily and rapidly adopt PhysioMimix Organ-on-a-chip technology
All-in-one kit
Reliably reproduce our DILI assay in your workflow with high quality validated cells and reagent
Proven solution
Benefit from decades of expertise refined through years of industry collaboration
Human relevance

cn-bio.com/226


Bridge the knowledge gap between in vitro assays and human trials - what are you waiting for?
A viable solution for human-specific drug modalities visit cn-bio.com

GSK-3β inhibitors like lithium and other small molecules have shown neuroprotective effects by reducing tau phosphorylation and Aβ levels. Additionally, c-Jun N-terminal kinase (JNK) inhibitors are being explored for their role in preventing neuronal cell death.
In PD: LRRK2 inhibitors are a major focus. Mutations in LRRK2 are linked to both familial and sporadic PD and inhibiting its kinase activity has shown promise in preclinical models. Several highly selective and potent LRRK2 inhibitors are currently in development, with some advancing to clinical trials. These inhibitors aim to reduce the pathological effects of mutated LRRK2, such as perturbed vesicular trafficking.
In ALS: The development of MAP4K inhibitors has gained attention. MAP4K inhibitors, such as Prosetin,
The development of kinase inhibitors for neurodegenerative diseases has demonstrated promising potential in recent years
have demonstrated neuroprotective effects by protecting motor neurons from endoplasmic reticulum (ER) stress-induced apoptosis.
While several kinase inhibitors are in various stages of clinical trials, none have yet received FDA approval specifically for neurodegenerative diseases (Table 1). The development of kinase inhibitors for neurodegenerative diseases has demonstrated promising potential in recent years. These compounds are designed to cross the blood-brain barrier and have shown efficacy in preclinical models, with ongoing efforts to advance them to clinical trials.
Developing kinase-targeted drugs for the treatment of neurodegenerative diseases presents several unique challenges. One major issue is achieving specificity. Kinases have highly conserved ATP-binding sites, making it difficult to design inhibitors
that selectively target only the desired kinase without affecting others, which can lead to off-target effects and toxicity. Additionally, the blood-brain barrier poses a significant obstacle. It restricts the delivery of many potential therapeutic compounds to the brain, necessitating the development of drugs that can effectively cross this barrier. The complexity of kinase signaling networks in the brain is also a challenge, which means that inhibiting a single kinase may not be sufficient to produce a therapeutic effect. As a result, combination therapies are often required, which can complicate treatment regimens. Furthermore, the development of drug resistance is a concern, as cells can adapt to kinase inhibition through various mechanisms, including mutations and activation of alternative pathways. These challenges require innovative approaches in drug design, rigorous preclinical testing, and carefully designed clinical trials to develop effective and safe kinase-targeted therapies for neurodegenerative diseases.

We will soon see a boom in brain-computer interfaces. IDTechEX explores the techniques being developed and the wearables that support them
rain-computer interfaces (BCIs), a type of biotechnology commonly called neurobiotech, come in many forms. They can be noninvasive, integrated into wearable devices, or invasive, meaning they are implanted into the body to work nearer to the brain. A recent report from research company IDTechEx called Brain Computer Interfaces 2025-2045: Technologies, Players, Forecasts, looks at how BCIs read and interpret brain signals in applications such as device control, mind writing, and restoring mobility.
Wearing headphones could soon be much more than another way of listening to music, since they can be redesigned to interpret brain data to provide information for more optimised productivity. US-based Neurable is a specialist in this field and is on a mission is to create a BCI that is as useful as a smartphone in daily life, and even more personalised
to enhance users’ well-being.
Magnetoencephalography (MEG) helmets could measure magnetic fields around the brain created by the electrical activity of neurons. Such technology has previously been used in large scanning devices, but the emergence of helmets could allow neuroimaging and data about the brain’s activity to be collected more conveniently and functionally while people go about their daily activities. However, further developments would be necessary to adapt this into a consumer BCI device, as the brain’s magnetic fields may be difficult to detect outside of a shielded environment, which may be a barrier to MEG adoption.
An interface that operates on the surface of the brain with minimal invasiveness has been created by a company called Precision to visualise human thoughts. Its thin film technology can cover many areas of the brain, using electrodes to stimulate

and simultaneously record thought patterns and translate them into readable information.
Similarly, US-based Synchron uses a small device implanted into a vein to send neurological messages to a separate unit fitted in the chest. The technology can use patients’ thoughts to create clicks and movements on a computer to enable communication without the need for speech or hand movements.
California-based Neuralink has developed a small implant designed to be inserted into the brain which could be used to utilise brain activity in people with movement impairments or paralysis. The Neuralink chip uses tiny electrodes within the brain to allow thought-based device control, with the company hoping to create never before seen possibilities for people living with quadriplegia.



Allowing devices to be user-friendly and accessible while maintaining a high functionality and ability to achieve the best quality data is one of the main challenges outlined by the report. Patient welfare will also remain a top priority with experimental technologies, meaning regulation of such invasive processes will likely be strict. The expense of BCI technologies could also be a barrier to adoption. However, IDTechEx predicts the brain computer interface market to exceed US$ 1.6bn in 2045, highlighting the large scope for growth and development within the sector.
For more information, visit IDTechEx’s latest report: www.IDTechEx.com/BCI




Creative Biolabs has launched its full panel of neuroscience assay solutions


A new panel of assay solutions promises to facilitate a greater understanding of the nervous system
Provider of research services for the neuroscience community, Creative Bioloabs, has released its full panel of neuroscience assay solutions.
These technologies aim to facilitate a greater understanding of the nervous system, resulting in potential breakthroughs in neurological disorders research.
One significant component of Creative Biolabs’ assay services is the neurotoxicity screening service. With the neurotoxicity screening service, a dose-response curve for neurotoxicity and drug efficacy can be obtained against various cell types.
This is crucial during early-stage central nervous system (CNS) drug discovery for the identification of potential toxic impacts of drug candidates.
Neurotoxicity screening is a relatively new field, and its progress is limited by factors that complicate neurotoxicology assessment. It has been proven that episodes of neurotoxic illness can be induced by chemicals, such as Lucel-7. According to the analysis of structure-activity relationships (SARs), only a small fraction of neurotoxicants can be identified. In this case, a series of invivo and in-vitro tests are necessary.
Compared with other organ systems, the nervous system exhibits a more complex cell structure and chemical heterogeneity. To examine all aspects of the human nervous system as comprehensively as possible, it is necessary to perform neurotoxicity tests using multiple cell types.
Based on our neurotoxicity screening platform, a dose-response curve for neurotoxicity and drug efficacy can be obtained against a variety of cell types. In recent years, multi-well microelectrode arrays (mwMEAs) have been used for neurotoxicity screening with high sensitivity and specificity.
“Highlights of our assay services include high reproducibility to deliver precise results, fast and cost-effective service to accelerate the drug discovery process, and characterisation of differentiated neuronal cells by state-of-the-art approaches such as whole-genome profiling and immunocytochemistry (ICC),” said a Creative Biolabs scientist.
Creative Biolabs offers the development of induced pluripotent stem cell (iPSC) lines and differentiation into an array of neural cell types, including dopaminergic neurons, GABAergic neurons, microglia, astrocytes, oligodendrocytes, and specialised cell types.
Further assisting neuroscience
research is the introduction of Creative Biolabs’ multi-electrode array (MEA) measurement services.
The easy-to-use MEA systems have real-time visualisation and analysis software to support accurate measurement services.
“Our MEA systems use a matrix of microelectrodes, which can be platinum or titanium and are insulated for precision, to record neuronal electrical activity,” said the scientist.
“Researchers have the option of high-density arrays to record minute information about the neurons or lowdensity arrays for an overview of large networks in experimental applications with varying requirements.”
Creative Biolabs offers comprehensive training and technical support for the technology’s experimental design, data analysis and troubleshooting.
In addition to these core services, Creative Biolabs provides a variety of related neuroscience research services, including monitoring of neuronal activity, calcium assays, high-content screening, ion channel screening, immunostaining services, sparselabelling services, and high-throughput phenotypic screening services.
• Resprep SPE & Q-sep QuEChERS
• PFAS Delay Columns
• Raptor & Force LC Columns
• PFAS Reference Materials
• Ultra-Clean Resin for Air Analyses
• ASE Cells & Parts
• Filters and vials
Access expert support and tailored PFAS testing solutions for U.S. EPA, ISO, ASTM methods, and more, at www.restek.com/PFAS

How dual-bed cartridges with filter aid help streamline solid-phase extraction during sample preparation
Effective sample preparation is essential for accurate trace-level PFAS analysis in complex sample matrices, such as non-potable waters, solids, biosolids, and tissues. Solid phase extraction (SPE) is typically used, but good results are difficult to achieve if background PFAS are present or if sample components clog the SPE cartridges. EPA Method 1633, which has been validated in multiple laboratories, uses a woolpacked weak anion exchange (WAX) cartridge for matrix extraction, followed by a dispersive graphitised carbon black (dGCB) cleanup step, with many labs adopting a carbon cartridge instead of using dGCB. While effective, this two-cartridge approach with manually-packed wool adds extra time, complexity, and risk

streamlined significantly with dual-bed
A dual-bed Resprep
of introducing contaminants to the sample preparation process.
RESPREP PFAS CARTRIDGES ARE A SIMPLER SOLUTION
PFAS SPE sample preparation can be streamlined significantly with dual-bed Resprep PFAS cartridges, which combine SPE extraction and carbon cleanup into a single cartridge. In this fast, simple workflow, the ultra-clean WAX and CarboPrep Plus sorbents used in



Introducing Unity, the world’s first combined Backscattered Electron and X-ray (BEX) imaging detector.
Accelerate your journey to scientific discovery with instant microstructural and chemical images, acquired simultaneously with the Unity detector.





out how we’re making sophisticated sample analyses simpler and faster than ever before.


Table II: When cartridges are packed manually following the height-based instructions in Method 1633, the amount of glass wool and packing density can vary significantly between cartridges and technicians, which can affect method performance
Resprep PFAS cartridges ensure that method performance requirements will be met. In addition, an optional, factory-packed filter aid eliminates the time and variability associated with manually packing glass wool. This ready-to-use solution prevents clogging so that even dirty matrices can be processed quickly with a single extraction.
Developed specifically to help labs meet PFAS performance requirements, dual-bed Resprep PFAS cartridges contain ultra-clean, high-quality WAX and carbon sorbent layers that provide effective extraction and cleanup. Every lot of Restek’s WAX sorbent is tested against Method 1633 PFAS analytes to demonstrate cleanliness and to ensure it does not contribute background PFAS. In addition, our high-performance CarboPrep Plus sorbent provides more effective and consistent cleanup than other carbon materials. The combination of both sorbents in a single cartridge makes sample preparation much faster and results in clean extracts and excellent analytical performance (view these results in Table 1 here).
Table I: Target recoveries (70-135%)
Our
provides more effective and consistent cleanup than other carbon materials
were met for all PFAS in reagent water samples prepared using Resprep PFAS cartridges.
Exclusive to Restek, Resprep PFAS cartridges are also available with a factory-packed filter aid that prevents clogs and keeps samples flowing better than manually packed glass wool. As shown in Table II, when technicians follow Method 1633 instructions to pack glass wool to half the height of the cartridge barrel for all sample matrices (Section 12.1.1), the amount of wool and packing density can vary
significantly, which means sample flow and clogging can also be affected. The filter aid used in Resprep PFAS cartridges is uniform and provides effective, consistent filtering and protection. In an experiment comparing the flow of diluted ASTM wastewater matrix through Resprep PFAS cartridges with filter aid, WAX cartridges with manually packed wool, and WAX cartridges alone, only the Resprep PFAS cartridges with the factory-packed filter aid did not clog and were able to extract the full sample volume (Figure 1).

Moisture content and particle size distribution can affect sticking

Sticking and picking are common issues within tablet production, this article explores how the right technology can circumvent the problem
Sticking is a common issue, it occurs when particles adhere to the punch cup while picking occurs where particles stick in or around the embossing on the punch face.
When sticking or picking is noticed, their location will help in identifying the root cause. Photos or sample tablets are helpful.
Cup depth is a critical parameter in optimising a tablet design. Often, sticking and picking is caused by a ‘soft zone’ across the crown of the tablet owing to a deep cup depth.
Shallower cup depths improve tablet hardness uniformity, which can reduce or eliminate the ‘soft zone’.
Picking is affected by the font style and letter spacing. Serif fonts are more prone to picking problems than Sans Serif fonts.
Fonts should have a letter height at least five times (preferably 6 to 7.5 times) stroke width to allow for adequate island and peninsula sizes. Inside corners within the font should have a fillet radius at least 20% of the stroke width. Opening up the shape and flair of
peninsulas rather than a more closed ‘pinch’ look is helpful. This may often be achieved by widening the letter, such as an ‘N’ or ‘M’, or uncurling the ends of an ‘S’.
Section thru engraving views detail stroke width, stroke angle, stroke depth, the blend radius, and the stroke radius. Wider stroke angles reduce picking, Avoid 30° for sticky formulations. 35° to 40° stroke angles are recommended with 37.5° or 40° used when adequate stroke depth can still be achieved. For sticky products, stroke depth should be the minimum necessary to achieve visual clarity. Stroke depths between 0.007” to 0.009” are preferred. For larger characters, use a flat bottom engraving to minimise stroke depth.
The blend radius is most often overlooked. Picking begins at the transition between the cup and logo. Larger blend radii improve resistance against picking. Specifying a blend radius that consumes 30% to 35% of the stroke depth is ideal for sticky products.. The formula to optimise break radius is:



Increased compression force and dwell time are helpful to reduce sticking and picking
Pre-picking decreases the height of the resulting island or pad, which can reduce or eliminate picking inside islands. Do not exceed more than 30% pre-pick on coated tablets.
Characters that do not have fully enclosed areas are also prone to picking. Tapering peninsulas starts at the internal corner and ramps up to the tablet surface.
The size and spacing of the characters can be modified to reduce picking. Best practice for spacing between characters is a minimum of one stroke width apart with 1.5 times the stroke width as optimum. Moving the placement of the characters off centre on a curved face tablet can also be helpful.
If sticking has been observed, specialty grade steel types or coatings may be considered to help eliminate these issues.
It is widely accepted that high chromium punch steels, such as M340, are beneficial for sticky products because the high chrome content yields improved product-release characteristics.
In some cases, a coating may be advantageous to address sticking/ picking. The most common are Hard Chrome & Chromium Nitride. A sticking assessment with an FT4 rheometer is recommended to compare the propensity of sticking between a specific formulation and different steels or coatings.
Other factors can affect sticking, including moisture content, lubricant %, particle size distribution (PSD), and fragmentability. Generally, excessive moisture can increase sticking or picking. While increasing the amount of lubricant can improve product release, too much or over-blending the lubricant will impair tablet bonding. Fines (particles below 76 microns) should be minimised. Using particles that can fragment during compaction improves bonding.
Increasing compression force and
dwell time are often helpful in reducing sticking and picking. Extended head flats can increase dwell time improving bonding for strain rate sensitive (SRS) formulations. Both increased compression forces and extended dwell times can help to reduce sticking.
An overlooked cause of sticking is using a deeper than necessary fill cam or running the feeder too fast. Excessive recirculation or paddle speed can cause segregation and generate fines in the feeder impairing formulation performance. It is best practice to use the shallowest fill cam and slowest feeder paddle speed that can still achieve consistent target tablet weight.
Consulting with a qualified tooling vendor and discussing sticking issues early in the development process will help reduce production issues.
AUTHOR:
Todd Martin, senior technical service engineer Natoli

Handling small amounts is crucial in the development of oral solid dosage (OSD) forms. Efficiently defining formulation and process parameters with minimal material reduces development costs, accelerates time to market, and enhances sustainability. Granulation, a pivotal step in OSD manufacturing, transforms powders into free-flowing, uniform granules. Dry granulation, in particular, is recognised for its simplicity, speed, and efficiency in OSD development.
Typically, dry-granulation equipment is designed and built for large scale to overcome flowability issues of the poorly flowing powder. Large scale equipment used to come with the downside of not being able to handle small amounts efficiently. High yields are hard to achieve owing to the large surface and potential loss area of the equipment. Furthermore,
achieving a steady process as fast as possible is essential to avoid out-ofspecification output.
One approach to address early-stage development challenges is the use of compaction simulators. These tools, combined with modern modelling techniques such as those based on the thin-layer model or Johanson’s work, facilitate the transfer of results to production-scale roller compactors. However, this method necessitates certain compromises. Correction factors must be determined to allow a scale-up from the compaction simulator to the roller compactor. These factors are essential for scaling up from the simulator to the roller compactor but require valuable material and introduce model uncertainty.
An alternative approach involves the use of small benchtop roller compactors. These compactors, characterised by smaller dimensions and reduced surface area, enable high yields when processing small amounts
of material. Despite their advantages, benchtop roller compactors face similar flowability issues as tableting equipment, and exhibit reduced drawin capabilities due to their reduced dimensions. These limitations can lead to the erroneous conclusion that roller compaction is unsuitable for certain products, despite potential success with full-scale equipment.
Utilising full-scale roller compactors for small-scale development circumvents the need for modelling and mitigates the risk of false assumptions. By implementing several modifications to standard equipment, the process can be optimised to handle small quantities efficiently, achieving high yields and rapid steady-state conditions. In dry granulation, press force and gap are critical parameters influencing product characteristics. The flexible gap system maintains constant press

force regardless of material feed rate resulting in a stable gap by regulating the feed rate. This stability is essential for reliable trial results with limited product quantities.
The introduction of an ultra small amount funnel facilitates stable gap achievement with material quantities ranging from 10g to 100g. Core principle of the ultra small amount funnel is replacing the feeding unit with a funnel using the roll surface
for feeding. No augers are required for material transport. An adjustable gate opening allows the setting of different gap values. Figure 1 demonstrates the rapid stabilisation of a 50g material batch using the ultra small amount funnel installed on a standard R&D Mini-Pactor, which also supports production throughput of 100kg/h. The funnel allows seamless scaling from small trials to fullscale production without equipment

small-scale mill supports development processes even without a roller compactor
transfer, ensuring repeatable results independent of the operator and avoiding transfer modelling.
Figure 2 illustrates the ultra small amount funnel’s effectiveness, achieving a 98% yield when processing 10g of material and collecting ribbons before milling. This effectiveness is achieved by avoiding any loss in the inlet funnel, feeding unit and milling area. Yield further increases with larger batch sizes.
The small scale mill, optimised for high-yield small amount trials, mirrors the design of the Pactor series’ oscillating mill, ensuring equivalent milling results. Key features such as rotor, screen type, mesh size, and screen distance are consistent, offering various screen types to meet different specifications. The manually operated milling bars process material through screens in the milling chamber, with fully processed granules collected in a drawer.
The small-scale mill supports development processes even without a roller compactor. Milling tablets produced on a compaction simulator or single punch press helps determine granule properties for later-stage dry granulation processes. The design emphasizes ease of use, with quick fitting and cleaning of components, and compliance with pharmaceutical regulatory guidelines.
The combination of the ultra small amount funnel and the smallscale mill provides a highly efficient solution for small amount trials in OSD development. This integrated approach ensures high yield, process stability, and scalability from R&D to full-scale production without modelling uncertainty. By optimising the granulation process for small quantities, pharmaceutical companies can reduce development costs, accelerate time to market, and enhance sustainability, ultimately benefiting both the industry and patients.
AUTHORS: Michael Schupp, Head of Process Engineering, Gerteis Maschinen + Processengineering AG
Figure 1: 3D heatmaps of polarisation-resolved Raman spectra in PE foil before (left) and after stretching (right). Labelled Raman peaks: (1) asymmetrical C-C stretching, (2) symmetrical C-C stretching, (3) CH2 twisting, (4) CH2 bending, (5) C-H stretching

Thomas Meyer, Ute Schmidt, Stefan Kreißl and Judith Beer from Oxford Instruments present polarisation-resolved Raman analyses that reveal the structural organisation in polymer and geological samples
Resolving the organisation and orientation of molecules in a material is essential in various research fields. From retracing the formation of naturally occurring structures to tailoring the chemical and physical properties in synthetics, structural analyses are the basis for many applications in geology, biology, pharmacology and material sciences. Polarisationresolved Raman spectroscopy is a powerful tool to unveil these structural characteristics in a nondestructive and efficient way.
Polarisation is a property of light that describes the directionality of the electric field vector in a light wave. Polarisation-resolved Raman spectroscopy uses this feature, as certain vibrational modes of molecular bonds detected in Raman spectroscopy are sensitive to the light’s polarisation angle. If these molecular bonds are oriented similarly in a sample, the Raman signal intensities vary with
changing polarisation angles of the excitation light. This can provide profound information on the sample’s molecular structure and organisation of different domains.
For polarisation-resolved Raman analyses, it is necessary to have suitable instrumentation that enables stable and precise control of the polarisation angle in the beam paths. A polarisation module can rotate incident linearly polarised light to the desired orientation. Polarisation filters in the detection beam path allow for the selection of the polarisation state of the scattered light. In the presented measurements, an Oxford Instruments WITec alpha300 Raman microscope with an automated polarisation module was used to record a 360° polarisation rotation series.
Polyethylene (PE), a versatile synthetic polymer used for the creation of plastics with diverse
Figure 2: Polar plots of the biotite νTO4 stretching and δT6O6 ring modes in two areas of a black mica cross section. Left: Measurement positions. Right: Polar orientation plots with data fits (lines).

physical properties, exhibits a molecular fibre structure. In an experiment conducted at the Empa, polarisation-resolved Raman spectroscopy was employed to investigate the effects of a pulling force on the PE molecules in a plastic foil. The foil was stretched from an initial length of 15 mm to 40 mm, and a full polarisation series was recorded by obtaining a Raman spectrum at every degree (total 360 spectra per condition) using a 532 nm excitation laser and a 50x/0.55 LWD objective.
The obtained Raman spectra (Figure 1) exhibited characteristic peaks related to the vibrational modes of PE, including the asymmetrical C-C stretching (1063 cm-1), symmetrical C-C stretching (1130 cm-1), CH2 twisting (1297 cm-1), CH2 bending (1417, 1441, and 1464 cm-1), and C-H stretching (2,849 and 2,883 cm-1). Notably, after stretching, the Raman bands associated with CH2 bending and C-H stretching showed polarisationdependent intensity changes. The signals for the C-C stretching mode also exhibited polarisation-dependent effects, but in an inversed pattern. These findings suggest a pulling force-induced alignment of PE fibres, with the C-C and C-H bonds pointing to perpendicular directions.
The crystallographic structure of minerals in a rock gives valuable insights into the geological formation processes. In this example, polarisation-resolved Raman spectroscopy revealed regions of different biotite alignments in a black mica biotite cross section that indicate separate phases in rock formation. Polarisation series were recorded from each 5 biotite grains of two areas of the cross section, obtaining one Raman spectrum every 5° through a full rotation, using a 532 nm excitation laser and a 50x/0.8 NA objective. The polar plots in Figure 2 display the Raman intensities of the crystal’s νTO4 stretching (green) and δT6O6 ring modes (blue) at the marked positions relative to the polarisation angle. For each individual position, a bipolar pattern is visible, caused by the anisotropic crystal structure in biotite grains. In region (i) (upper panel), the single patterns show no preferred angle in the polar plots, indicating a random orientation of the grains. In contrast, the polar plots from the measurement positions in area (ii) (lower panel) follow the same direction, with the νTO4
stretching mode perpendicular to the δT6O6 ring modes. This reveals the high alignment of biotite crystals in this region, a structure that was induced by high pressure during rock formation. The random organisation in region (i) originates likely from a later event of magmatic infiltration and undirected crystallisation.
Polarisation-resolved Raman analyses unveil information about molecular orientation, crystallographic alignments, and anisotropy in materials. A Raman microscope that enables controlling and selecting the polarisation angle of light is thus a valuable tool for structural analyses in diverse scientific fields.
AUTHORS:
Thomas Meyer – Senior Application Scientist – Oxford Instruments
Ute Schmidt – Applications Manager – Oxford Instruments
Stefan Kreißl – Application Scientist – Oxford Instruments
Judith Beer – Technical Marketing Specialist – Oxford Instruments



Fair access to technical career progression is key to sustaining the skills needed for the lab technicians of the future, argues
Jiteen
at Aston University
Looking back five years, I would never have anticipated that the pandemic lockdown could help advance the technical profession in UK academia and research. But it did.
Within weeks of launching the Research England funded TALENT Programme in March 2020, lockdowns were put in place and technicians were the people maintaining laboratories, managing research equipment, 3D printing ventilator parts and visors, carrying out compliance checks and supporting the rapid pivot to remote learning.
The unprecedented circumstances shone a light on the critical value of technical contributions in academia and research, supporting TALENT’s vision to advance status and opportunities for the workforce.
Covid aside, this programme was the largest ever investment into UK technical careers, at the time, and has since achieved tangible and transformational change for the technical workforce.
There was a huge knowledge gap about technicians in the sector. What is a technician, what do they do, where do they work? The breadth and depth of technical roles and careers have made defining the community challenging, and the lack of standardised job roles and titles in the sector also contributed to this.
TALENT published six research reports providing new insights into the technical workforce. The most significant, the TALENT Commission, provides new strategic data on the workforce and sets out a blueprint for the future of UK technical skills, roles and careers.
I have personally seen changes at Aston University as a direct result of TALENT. More technical staff are being recognised as co-authors on research papers. Technicians are being named as inventors on patents, which have since commercialised to a multi-million-pound spinout company. Our technicians are becoming coinvestigators on research grants offered through the Biotechnology and Biological Sciences Research Council (BBSRC). Technicians’ voices are also being heard on decisionmaking boards, such as the Senate, senior management and health and safety committees.
At Aston University, we are exploring new technical career pathways to unlock progression opportunities that simply didn’t exist before.
The University of Liverpool, University of Warwick and Loughborough University have also made changes to organisational structures to improve recruitment, retention and recognition of technical professionals.
Having started as a regional programme for technicians in the eight Midlands Innovation universities (Aston, Birmingham, Cranfield, Leicester, Loughborough, Keele, Nottingham, Warwick), the pilot initiatives have gained traction. Now the focus is on sharing this success with other institutions so they can see the wider benefits of investing in their technical workforce.
The UK Institute for Technical Skills & Strategy (UK ITSS) is taking the most successful initiatives from TALENT and scaling them out nationally. Including pioneering leadership programmes to technicianled equipment sharing and knowledge exchange placements.
In collaboration with the Technician Commitment, UK ITSS continues to foster a culture where technical professionals are fully recognised and valued.
To avoid a widening gap between institutions which commit to championing the role of technicians, and those which don’t, we need buy-in across the whole system to achieve sustainable changes that will strengthen technical skills and capacity.
For more information visit: www.itss.org.uk














































































3D Raman image of a pharmaceutical ointment.

































Let your discoveries lead the scientifi c future. Oxford Instruments WITec’s confocal 3D Raman microscopes enable cutting-edge chemical imaging, Raman-based particle analysis and correlative integration with SEM, AFM, SNOM or optical profilometry. Discuss your ideas with us at info.witec@oxinst.com


The European Society of Human Genetics (ESHG) 2025 conference will take place in Milan on 25-27th May at the Allianz MiCo, Milano Convention Centre. The conference also took place in 2014 and 2018. The programme aims to reflect the broad church of ESHG members and will include educational sessions, symposia invited speakers and training sessions. As a hybrid conference, participation will be available to those that can’t make it to Milan in person. Attendees can participate in-person or online
through a dedicated ESHG virtual conference platform, ensuring ensuring access is as wide as possible.
With many social and networking events, the conference aims to help attendees develop collaborations with sponsors and exhibitors, helping them learn about the new technological and commercial offerings in the space.
Pre-conference courses run from 22nd May and include ‘Clinical NGS data interpretation’; ‘Unleashing the power of large scale genomic public databases’; and, ‘A professional development workshop looking at
new approaches to genetic teaching’. Sessions will include plenary, concurrent symposia and workshops. Participants can only register for the full conference and it is not possible to book day tickets.
Official events will include the Opening Network Mixer; the Young Human Geneticists Networking Event; and the ESHG Networking Event.
For more information visit: https://2025.eshg.org/



Creative Biolabs
A leading global supplier, offers highquality biological products like recombinant antibodies, membrane proteins, and cell lines, and custom services in therapeutics discovery to support your research needs.
T 1-631-416-1478
E info@creative-biolabs.com
W www.creative-biolabs.com

INTEGRA Bioscience
INTEGRA is a leading provider of high quality laboratory tools and consumables for liquid handling. We are committed to fulfilling the needs of laboratory professionals in research, diagnostics, and quality control within the life sciences industry.
T +44 (0) 1635 797000
E info-uk@integra-biosciences.com
W www.integra-biosciences.com

A Swiss manufacturer of advanced highquality pharmaceutical roller compactors. Our understanding of the dry granulation process combined with patented roller compaction systems make Gerteis® the technology leaders in the field of dry granulation.
T +41 (0)55 222 55 22
E sales@gerteis.com
W www.gerteis.com

L.B.Bohle
Headquartered in Germany, a leading system supplier for the pharmaceutical industry. We provide sustainable machines and processes for efficient batch and continuous manufacturing, ensuring high-quality solutions for demanding production needs.
T +492524 – 93 23 0
E info@lbbohle.de
W www.lbbohle.com

Manufacturer of optoelectronic components and systems. Including sensors and systems for spectroscopy (inc. ultrafast), scientificgrade cameras, beam monitoring systems, photon-counting detectors and systems, photomultipliers, photodiodes and IR detectors.
T (49)8152-375-0
E info@hamamatsu.eu
W www.hamamatsu.com

PHC Europe
As part of PHC Group, we provide high-quality laboratory equipment for biomedical and diagnostic applications, ensuring precision, reliability and performance. We offer expert service, certification and innovative solutions for life science, healthcare and industrial sectors.
T +31 76 5433833
E marketing@eu.phchd.com
W www.phchd.com/eu/phceu

Restek
Chromatography is what we do and who we are. From LC and GC columns to sample preparation, standards to accessories, Restek is your first and best choice. Restek is Pure Chromatography.
T 1-814-353-1309
E crm@restek.com
W www.restek.com
A global leader in manufacturing affordable, high-quality reagents, including recombinant proteins, antibodies and cDNA clones in-house.
T +49 (0)6196 9678656
E marketing@sinobiological.com
W www.sinobiological.com















Biotech Fluidics can support your high-precision fluidic instrument development project. At any scale, anywhere, anyhow. Contact Biotech Fluidics today to discuss your system ideas.
